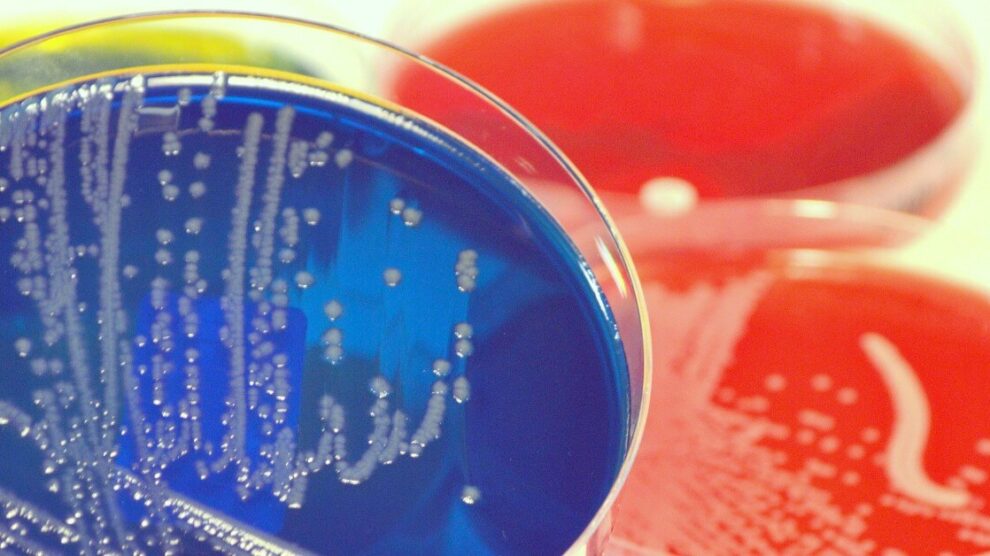
Problemy z mikrobiomem u dzieci 1 990x556

Jakie są przyczyny problemów z mikrobiomem u dzieci?
Spis treści:
Nota redakcyjna: Naturazdrowie.com ma charakter wyłącznie edukacyjny i nie stanowi porady lekarskiej. Redakcja dokłada wszelkich starań, aby publikowane informacje były poprawne merytorycznie, jednakże każda decyzja dotycząca leczenia powinna być skonsultowana z lekarzem. Regulamin serwisu












